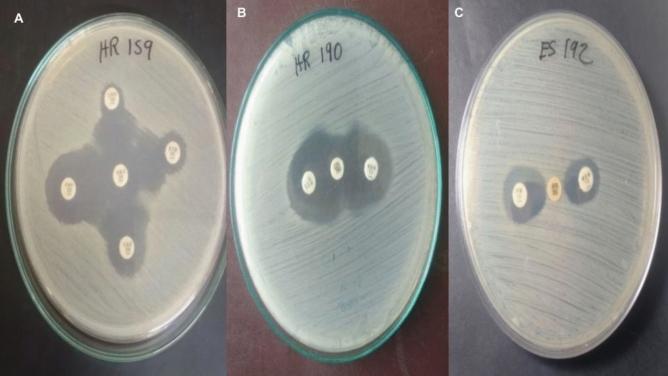
https://cdn.ncbi.nlm.nih.gov/pmc/blobs/4755/12037762/982bf5e4a6ab/41598_2025_97464_Fig1_HTML.jpg
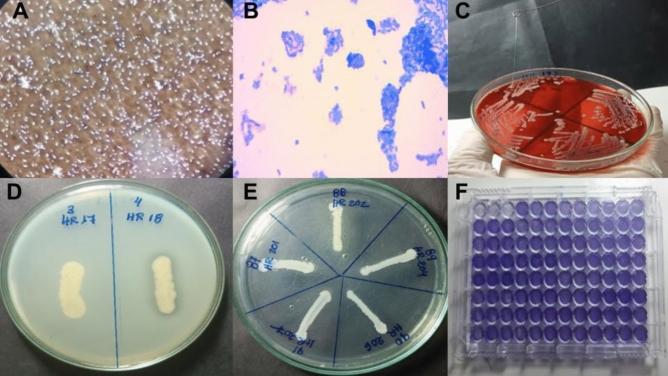
https://cdn.ncbi.nlm.nih.gov/pmc/blobs/4755/12037762/7bd5910482ab/41598_2025_97464_Fig2_HTML.jpg

从秘鲁南部分离出的肺炎克雷伯菌中鉴定大流行ST147、超广谱β-内酰胺酶、碳青霉烯酶和毒力因子。
Identification of pandemic ST147, ESBL-type β-lactamases, carbapenemases, and virulence factors in Klebsiella pneumoniae isolated from southern Peru.
作者信息
Aguilar-Ancori Elsa Gladys, Marin-Carrasco Marishani, Campo-Pfuyo Laura Isabel, Muñiz-Duran Julia Griselda, Espinoza-Culupú Abraham
机构信息
Faculty of Biological Sciences, Universidad Nacional de San Antonio Abad del Cusco, Cusco, Peru.
University Institute of Tropical Diseases and Biomedicine of Cusco, UNSAAC, Cusco, Peru.
出版信息
Sci Rep. 2025 Apr 28;15(1):14870. doi: 10.1038/s41598-025-97464-8.
Multidrug-resistant Klebsiella pneumoniae (MDR K. pneumoniae) is a significant pathogen associated with nosocomial infections, often leading to high morbidity and mortality. This resistance is largely due to the efficient horizontal transfer of mobile genetic elements such as plasmids, which carry resistance genes and virulence factors. These elements contribute to the production of extended-spectrum β-lactamases (ESBL) and carbapenemases, which further complicates treatment. Despite the high prevalence of MDR K. pneumoniae in Peruvian hospitals, the genomic characterization of these strains remains limited. This study investigated the phenotypic and molecular identification of extended-spectrum β-lactamases (ESBLs), carbapenemases, and virulence factors in 91 MDR K. pneumoniae strains collected from three hospitals between 2022 and 2023. Phenotypic detection of ESBLs was performed using the Jarlier method, while carbapenemases were identified via double-disk synergy testing with boronic acid, EDTA, and Carba NP test. The positive isolates were further analyzed for resistance genes (blaCTX-M, blaTEM, blaSHV, blaKPC, blaNDM, blaIMP, and blaVIM). Four isolates were subjected to whole-genome sequencing (WGS) for further characterization. All multidrug-resistant K. pneumoniae strains (100%) were ESBL-positive, with 14.3% producing carbapenemases, primarily KPC-type and metallo-β-lactamases (MBLs). The virulence factor analyses revealed that only 7.7% exhibited hypermucoviscosity. Protease activity was detected in 19.8% of the strains, and lipase activity in 1.1%. Regarding biofilm formation, 85.7% of the strains showed moderate adherence. Molecular analysis identified ESBL (blaCTX-M, 78%; blaTEM, 71.4%; blaSHV, 82.4%) and carbapenemase genes (blaKPC 7.7%, blaNDM 4.4%). Genomic analysis revealed various antimicrobial resistance mechanisms, including porin-coding gene mutations, aminoglycoside resistance linked to fluoroquinolone resistance, and multidrug efflux pump regulators. Sequence typing has identified high-risk clones (ST147, ST629, and ST37) associated with hospital outbreaks globally. These findings underscore the considerable concern of MDR and hypervirulent K. pneumoniae in Peruvian hospitals. These findings emphasize the pressing need for sustained genomic surveillance, enhanced infection control measures, and strategies to address the expanding problem of MDR K. pneumoniae.
多重耐药肺炎克雷伯菌(MDR K. pneumoniae)是一种与医院感染相关的重要病原体,常导致高发病率和死亡率。这种耐药性很大程度上归因于质粒等可移动遗传元件的高效水平转移,这些元件携带耐药基因和毒力因子。这些元件导致超广谱β-内酰胺酶(ESBL)和碳青霉烯酶的产生,这进一步使治疗复杂化。尽管MDR K. pneumoniae在秘鲁医院中普遍存在,但这些菌株的基因组特征仍然有限。本研究调查了2022年至2023年间从三家医院收集的91株MDR K. pneumoniae菌株中超广谱β-内酰胺酶(ESBLs)、碳青霉烯酶和毒力因子的表型和分子鉴定。使用Jarlier方法进行ESBLs的表型检测,而通过与硼酸、乙二胺四乙酸的双盘协同试验和Carba NP试验鉴定碳青霉烯酶。对阳性分离株进一步分析耐药基因(blaCTX-M、blaTEM、blaSHV、blaKPC、blaNDM、blaIMP和blaVIM)。对四株分离株进行全基因组测序(WGS)以进一步表征。所有多重耐药肺炎克雷伯菌菌株(100%)均为ESBL阳性,14.3%产生碳青霉烯酶,主要是KPC型和金属β-内酰胺酶(MBLs)。毒力因子分析显示,只有7.7%表现出高黏液性。在19.8%的菌株中检测到蛋白酶活性,1.1%的菌株中检测到脂肪酶活性。关于生物膜形成,85.7%的菌株表现出中度黏附。分子分析鉴定出ESBL(blaCTX-M,78%;blaTEM,71.4%;blaSHV,82.4%)和碳青霉烯酶基因(blaKPC 7.7%,blaNDM 4.4%)。基因组分析揭示了各种抗菌耐药机制,包括孔蛋白编码基因突变、与氟喹诺酮耐药相关的氨基糖苷类耐药以及多药外排泵调节因子。序列分型已鉴定出与全球医院暴发相关的高风险克隆(ST147、ST629和ST37)。这些发现强调了秘鲁医院中MDR和高毒力肺炎克雷伯菌的严重问题。这些发现强调了持续进行基因组监测、加强感染控制措施以及应对MDR K. pneumoniae不断扩大问题的策略的迫切需求。